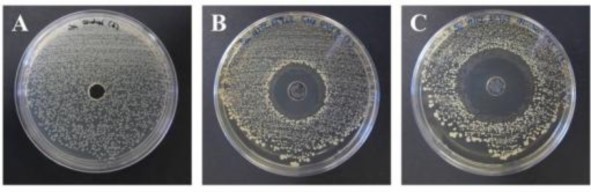
Hình 4 9 Mô hình đánh giá tính kháng khuẩn Kết quả của các kiểm tra tác dụng 1

4.3. ĐÁNH GIÁ CÁC CHỈ TIÊU CỦA CÁC CÔNG THỨC GEL NGHIÊN CỨU
4.3.1. Cảm quan
Chế phẩm dạng lỏng ở nhiệt độ thường.
4.3.2. pH
Thực hiện đo pH của dung dịch thuốc bằng máy đo pH thu được kết quả được trình bày ở bảng 4.8.
Bảng 4.8. Giá trị pH của chế phẩm ở 25
Công thức
pH
Lần 1 Lần 2 Lần 3 ̅
C7 6,05 6,02 6,02 6,03 3.10-4
Như vậy, công thức đạt pH như yêu cầu (khoảng pH 6,0).
4.3.3. Độ trong
Dung dịch trong, không có các tiểu phân quan sát được bằng mắt thường.
4.3.4. Giới hạn kích thước tiểu phân
DIG đạt giới hạn kích thước tiểu phân như yêu cầu không được có phần tử nào có kích thước lớn hơn 75 m.
4.3.5. Độ nhớt
Tại pH = 6,0, chế phẩm thuốc ở dạng lỏng và có độ nhớt thấp. Tại pH = 7,4, dung dịch chuyển sang dạng gel có độ nhớt cao. Như kết quả đã khảo sát ở bảng 4.5.
4.3.6. Thử kết dính sinh học
Khả năng kết dính sinh học của DIG được đánh giá theo phương pháp ở mục
3.2.3.7. Kết quả được trình bày ở bảng 4.9.
Bảng 4.9. Kết quả khả năng kết dính sinh học
Công thức
Khối lượng làm mất bám dính (g) Lực bám dính
Lần 1 Lần 2 Lần 3 ̅
(g/cm2)
C7 62,43 64,12 63,76 63,44 0,82 20,04 0,26
Như vậy, carbopol kết hợp với HPMC làm tăng độ nhớt của DIG, làm tăng khả năng bám dính của gel với niêm mạc.
4.3.7. Đánh giá tính kháng khuẩn
Tiến hành đánh giá như mô tả ở mục 3.2.3.9.
Hình 4.9. Mô hình đánh giá tính kháng khuẩn
Kết quả của các kiểm tra tác dụng kháng khuẩn được biểu diễn trong bảng 4.10. Bảng 4.10. Kết quả đánh giá tính kháng khuẩn
ZOI của dung dịch chuẩn d1 (cm) | ZOI của dung dịch thử d2 (cm) | Tỷ lệ % giữa d1 và d2 (%) | |
S. aureus | |||
1 | 1,5 | 1,4 | 93 |
10 | 2,8 | 2,4 | 85 |
100 | 3,6 | 3,6 | 100 |
500 | 5,6 | 4,7 | 84 |
P. aeruginosa | |||
1 | 0,5 | 0,5 | 100 |
10 | 1,2 | 1,2 | 100 |
100 | 3,5 | 3,0 | 85 |
500 | 4,2 | 4,0 | 95 |
Có thể bạn quan tâm!
-
Nghiên cứu xây dựng công thức điều chế thuốc nhỏ mắt gel in situ chứa 0,3 % ofloxacin - 1 -
Nghiên cứu xây dựng công thức điều chế thuốc nhỏ mắt gel in situ chứa 0,3 % ofloxacin - 2 -
Các Chỉ Tiêu Đánh Giá Gel In Situ Tạo Bởi Thay Đổi Ph -
Chỉ Định, Chống Chỉ Định, Tác Dụng Không Mong Muốn -
Xây Dựng Công Thức Cơ Bản Gel In Situ Chứa 0,3 % Ofloxacin -
Nghiên cứu xây dựng công thức điều chế thuốc nhỏ mắt gel in situ chứa 0,3 % ofloxacin - 6
Xem toàn bộ 63 trang tài liệu này.
Kết quả cho thấy rằng ofloxacin giữ được tác dụng kháng khuẩn khi được bào chế dưới dạng gel in situ.
4.3.8. Đánh giá khả năng giải phóng hoạt chất in vitro
Tiến hành đánh giá như mô tả ở mục 3.2.3.11.

Hình 4.10. Mô hình đánh giá khả năng giải phóng hoạt chất in vitro
Lấy mẫu ở những thời điểm xác định 1 giờ, 2 giờ, 3 giờ, 4 giờ, 5 giờ, 6 giờ.

Hình 4.11. Mẫu tại những thời điểm xác định
4.3.9. Độ ổn định
Trong 1 tháng, chế phẩm thuốc không có sự thay đổi các chỉ tiêu pH (khoảng 6,0), độ nhớt, giải phóng thuốc in vitro, khả năng tạo gel và tính bám dính niêm mạc.
CHƯƠNG 5. KẾT LUẬN VÀ ĐỀ NGHỊ
5.1. KẾT LUẬN
sau:
Sau thời gian thực hiện, đề tài đã đạt được các mục tiêu đề ra với những kết quả
1. Lựa chọn được tá dược để tăng độ tan của ofloxacin là dung dịch đệm citro –
phosphat pH 6,0.
2. Xây dựng công thức cơ bản gel in situ chứa 0,3 % ofloxacin.
3. Xây dựng công thức và quy trình điều chế gel in situ 0,3 % ofloxacin. Thành phần công thức 100 mL DIG
Ofloxacin 0,3 g
Carbopol 940 0,7 g
HPMC 1,0 g
Triethanolamin 0,43 g
Tween 20 1,0 g
Benzylkonium clorid 0,01 g Đệm citro – phosphat pH 6,0 vđ Nước cất vđ
4. Đánh giá được ảnh hưởng của các yếu tố trong công thức bào chế tới các chỉ tiêu chất lượng của dung dịch in situ gel: khả năng tạo gel, khả năng chảy lỏng, độ nhớt, khả năng kết dính, tính kháng khuẩn và độ ổn định.
5.2. ĐỀ NGHỊ
1. Tiếp tục nghiên cứu xây dựng quy trình định lượng ofloxacin trong chế phẩm bằng phương pháp HPLC
2. Tiếp tục hoàn thiện công thức bào chế DIG ofloxacin, nghiên cứu độ ổn định và tuổi thọ của DIG
3. Lựa chọn phương pháp bào chế trong môi trường vô khuẩn hay lựa chọn phương pháp tiệt khuẩn thích hợp cho DIG ofloxacin.
4. Thử hoạt tính in vivo.
TÀI LIỆU THAM KHẢO
1. Agrawal A. K., Das M. and Jain S. (2012). In situ gel systems as 'smart' carriers for sustained ocular drug delivery. Expert Opinion Drug Delivery. pp. 383 – 402.
2. Bangun D. H., Ariyana, Sinurat D., Ervina I. (2014). Formulation and in vitro Evaluation of Alginate Based Metronidazole Periodontal Gel. Asian Journal of Pharmaceutical and Clinical Research. pp 223 – 227.
3. Bộ Y tế . Dược điển Việt Nam IV. NXB Y học.
4. Bộ Y tế . Dược thư quốc gia. NXB Y học.
5. Clyder M. O. III and Klech-Gelotte C. M. (2007). Gels and Jellies. In: Encyclopedia of Pharmaceutical Technology 3 rd edition. Informa healthcare USA. New York. pp. 1875 – 1889.
6. Huỳnh Văn Hoá (2010). Bào chế và sinh dược học tập 2. NXB Giáo dục Việt Nam. Hà Nội. tr 73 – 124.
7. Kulkarni A. P., Khan S. K. A., Dehghan M. H. (2012). Evaluation of poloxamer based in situ gelling system of articaine as a drug delivery system for anesthetizing periodontal pockets: An in vitro study. Indian Journal of Dentistry. pp 201 – 208.
8. Lê Quan Nghiệm (2007). Sinh dược học và các hệ thống trị liệu mới. NXB Y Học. Thành phố Hồ Chí Minh. tr 87, 148 – 209.
9. Nagaich U., Jain N., Kumar D., Gulati N. (2015). Controlled Ocular Drug delivery of ofloxacin using temperature modulated in situ gelling system. Journal of the Scientific Society. pp 90 – 94.
10. Nguyễn Đăng Hoà (2009). Sinh dược học bào chế. NXB Y học. Hà Nội. tr 52
– 66.
11. Nguyễn Đăng Hoà (2013). Kỹ thuật bào chế và sinh dược học các dạng thuốc tập 1. NXB Y học. Hà Nội. tr 180 – 200.
12. Nguyễn Thanh Hà (2014). Nghiên cứu xây dựng công thức in situ gel diclofenac nhỏ mắt. Luận văn tốt nghiệp Dược sĩ. Đại học Dược Hà Nội. Hà Nội.
13. Nguyễn Thị Hồng Hương (2011). Kiểm nghiệm thuốc. NXB Giáo dục Việt Nam. Hà Nội. tr 285 – 296, tr 313 – 329.
14. Nguyễn Văn Long (2014). Kỹ thuật bào chế và sinh dược học các dạng thuốc tập 2. NXB Y học. Hà Nội. tr 43 – 90.
15. Nirmal H. B., Bakliwal S.R., Pawar S.P. (2010). In situ gel: New trends in Controlled and Sustained Drug Delivery System. International Journal of PharmTech Research. pp 1398 – 1408.
16. Phan Thanh Dũng (2013). Hoá phân tích tập 2. NXB Y học. Hà Nội. tr 238 – 262.
17. Preetha J. P., Karthika K., Rekha. NR and Elshafie K. (2010). Formulation and evaluation of in situ ophthalmic gels of diclofenac sodium. Journal of Chemical and Pharmaceutical Research. pp 528 – 535.
18. Rajoria G. and Gupta A. (2012). In situ Gelling System: A Novel Approach for Ocular Drug Delivery. American Journal of Pharmtech Research. pp 24 – 53.
19. Ramadan E., Borg Th., Hawary Y.M. El and Saleh N. M. (2010). Formulation and evaluation of metronidazole bioadhesive matrices for treatment of periodontitis. Bulletin of Pharmaceutical Science. pp 79 – 94.
20. Rathore K. S. (2011). Development and in vivo in vitro Characterizations of timolol maleate in situ gels. International Journal of Pharma and Bio Sciences. pp 248
– 263.
21. Raymond C. R., Sheskey P. J., Quinn M. E. (2009). Handbook of Pharmaceutical Exipients 6th Edition. Pharmaceutical Press and American Pharmacists Association. The United States of America. pp 110 – 114, pp 326 – 329.
22. Reddy J. and Ahmed M. (2013). Sustained ocular delivery of sparfloxacin from pH riggered in situ gelling System. Mahidol University Journal of Pharmaceutical Sciences. pp 16 – 25.
23. Srividya B., Cardoza R. M., Amin P.D. (2001). Sustained ophthalmic delivery of ofloxacin from a pH triggered in situ gelling system. Journal of Controlled Release. pp 205 – 211.
24. Trương Phương (2010). Hóa dược tập 1. NXB Giáo dục Việt Nam. Hà Nội. tr 146 – 160.
Website
25. Viêm giác mạc. http://www.kienthucnhankhoa.com/viem-giac-mac/. Truy cập ngày 30 tháng 3 năm 2017.
26. Mắt người. http://wit-ecogreen.com.vn/cau-truc-cua-mat.html. Truy cập ngày 30 tháng 3 năm 2017.
27. Thuốc nhỏ mắt ofloxacin. https://www.drugs.com/pro/ofloxacin-ophthalmic-solution.html. Truy cập ngày 05 tháng 4 năm 2017.






